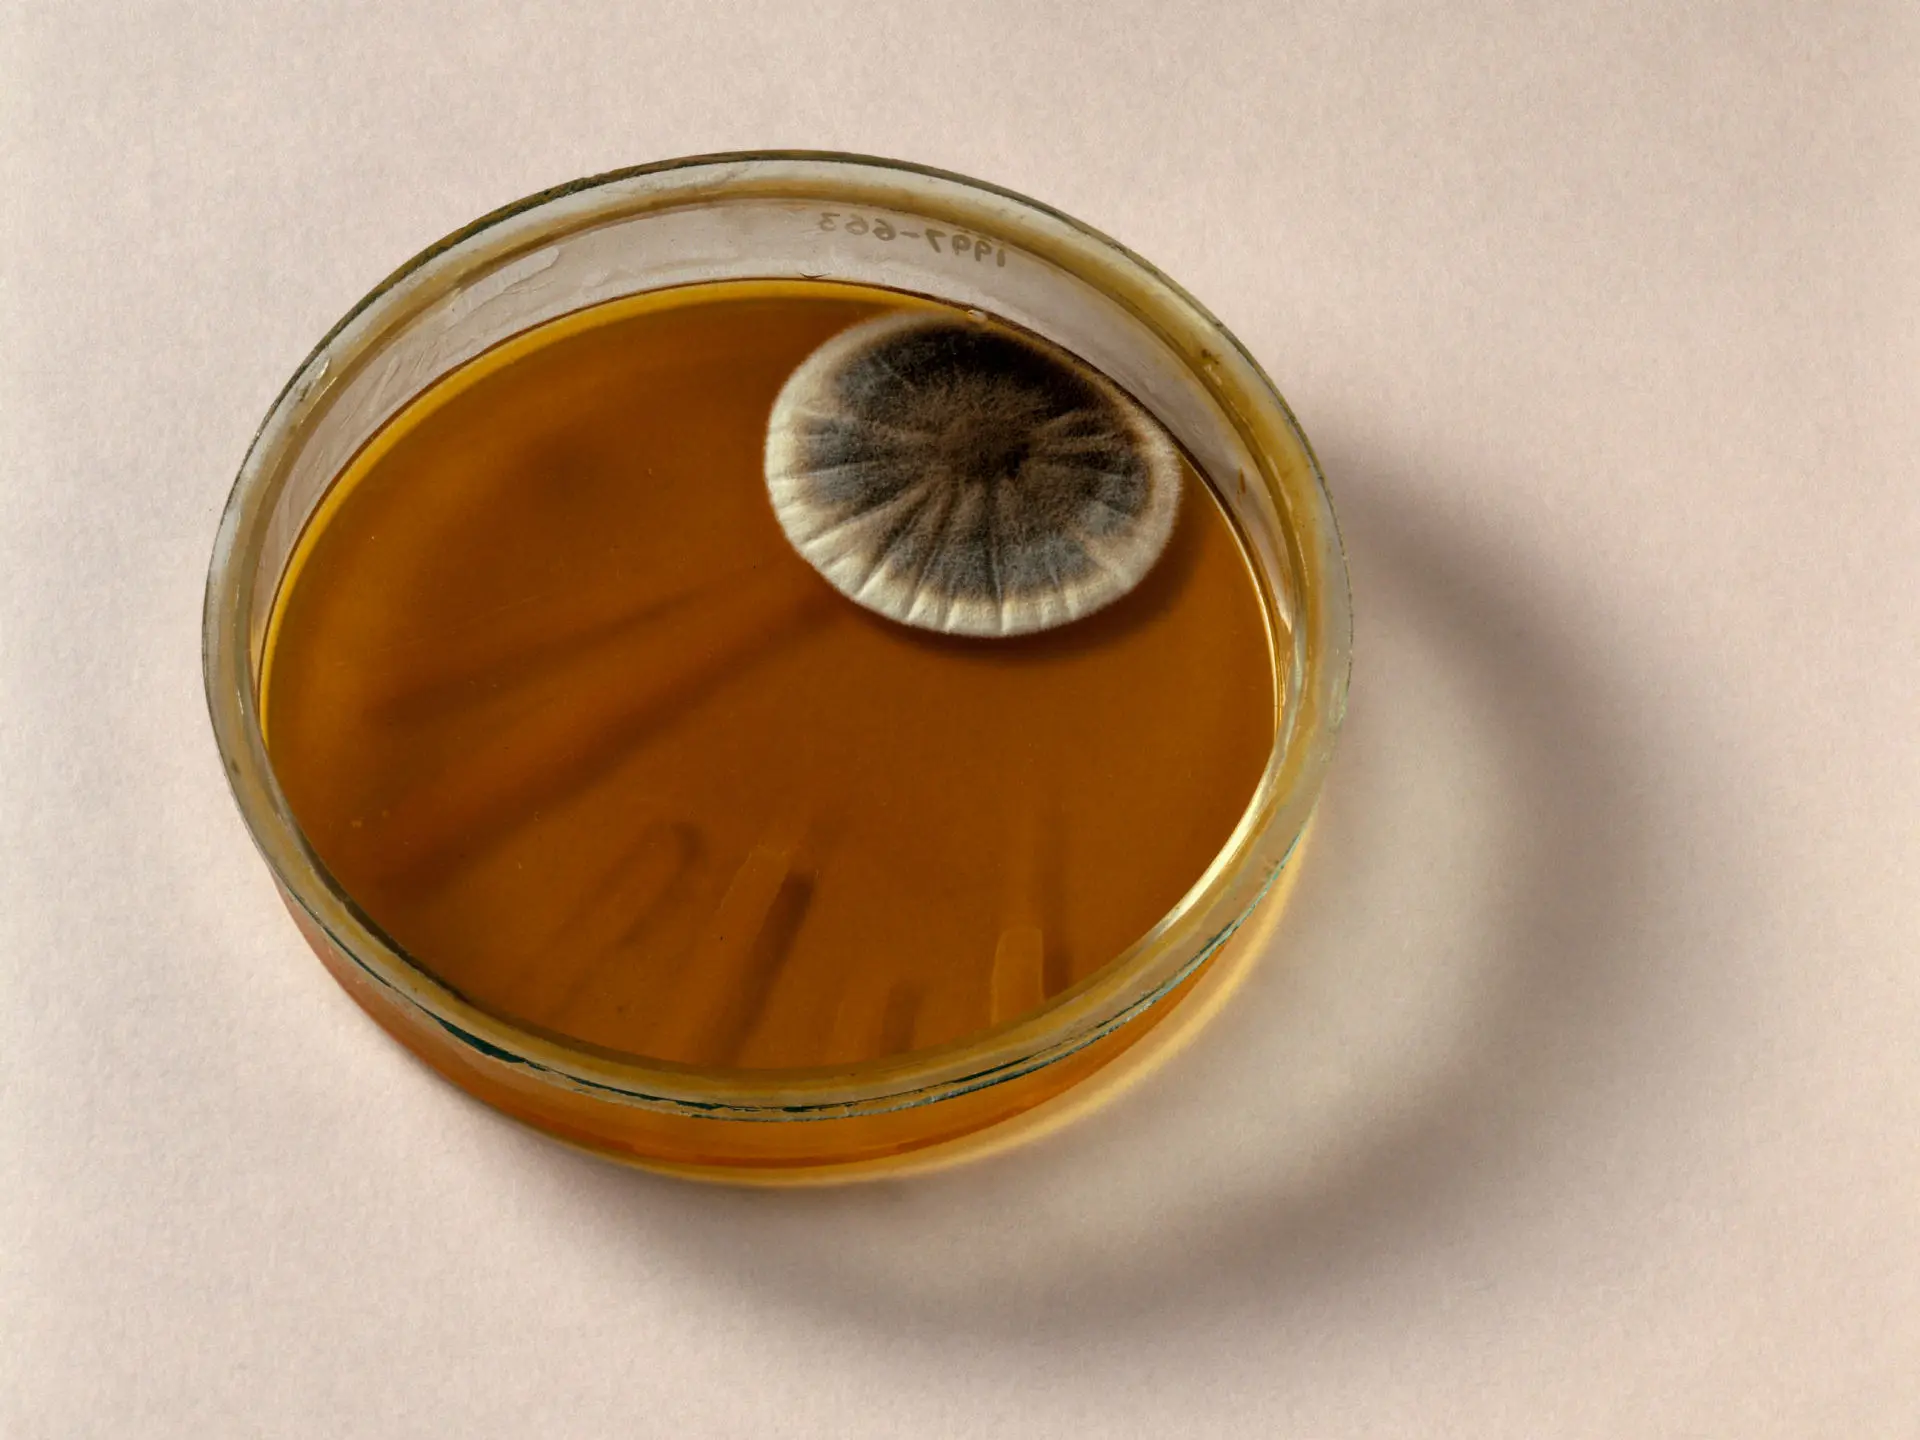

داستان کپکی سبز که جان میلیونها نفر را نجات داد

کشف تصادفی یک کپک در آزمایشگاه یک دانشمند اسکاتلندی در سال ۱۹۲۸، آغازگر انقلاب بزرگی در علم پزشکی شد؛ اتفاقی که جهان را با پنیسیلین، نخستین آنتیبیوتیک تاریخ، آشنا کرد و جان میلیونها نفر را نجات داد.
۲۸ سپتامبر سال ۱۹۲۸ میلادی، صبحی نو در لندن فرا رسید و الکساندر فلمینگ، پژوهشگر اسکاتلندی در حوزه میکروبشناسی، پس از دو هفته تعطیلات به آزمایشگاه کوچک و پر هرجومرج خود در بیمارستان بازگشت. روی میز کار او، تعداد زیادی ظرف پتری (ابزار کشت آزمایشگاهی) پخش شده بودند که نشان از عادت همیشگی فلمینگ در روی هم انباشت کردن ظرفها قبل از دور انداختنشان داشت.
آغاز یک کشف بزرگ
الکساندر فلمینگ آن روز صبح زود بیدار شد تا آزمایشهای مرتبط با رشد باکتریها را بررسی کند، بیآنکه بداند در آستانه یکی از مهمترین کشفیات تاریخ پزشکی قرار دارد. آزمایشهای او در اتاق کوچکی انجام میشد که گنجایش چندانی نداشت و تنها یک متر مربع فضا در بر میگرفت. او معمولاً ظروف حاوی باکتریهای مختلف را روزها، و حتی هفتهها، روی میز خود رها میکرد و بعد از رسیدگی به تکتک آنها، موارد اضافی را دور میریخت. اما آن روز، چیزی عجیب نظر او را به خود جلب کرد؛ کپک سبزی که روی یکی از ظروف کشت باکتری استافیلوکوک اورئوس ظاهر شده بود.
< ظرف پتری که حاوی کلونیهای باکتریایی است و کپک پنیسیلیوم در گوشهی بالای سمت راست آن رشد کرده است.
ظرف پتری که حاوی کلونیهای باکتریایی است و کپک پنیسیلیوم در گوشهی بالای سمت راست آن رشد کرده است.
کپک سبز و هاله شفاف
ظاهر شدن کپک سبز بر روی ظرف آزمایش، حادثهای غیرمعمول نبود. اما آنچه فلمینگ را به تأمل واداشت، حلقهای شفاف و بدون باکتری بود که اطراف این کپک را احاطه کرده بود. به نظر میرسید که باکتریها در این ناحیه تقریباً کاملاً از بین رفتهاند. فلمینگ، که به بینظمی مشهور بود، ناخواسته یکی از بزرگترین کشفیات علم پزشکی را شکل داده بود. این "شیره کپک" مرموز بعدها به نام پنیسیلین شناخته شد، مادهای که انقلابی در درمان بیماریها ایجاد کرد و زندگی میلیونها نفر را نجات داد.
این کشف تصادفی در ادامه بررسی نشان داد که این ماده جادویی از قارچی به نام پنیسیلیوم ترشح شده است. فلمینگ این رخداد را برای همکاران خود توضیح داد، اما این کشف در ابتدا توجه چندانی جلب نکرد؛ چرا که جداسازی ماده مؤثر از کپک فرایندی پیچیده و طاقتفرسا بود.
سالهایی طولانی از تلاش و آزمایش
کشورهای کمی به یافتههای فلمینگ توجه نشان دادند، تا اینکه در سال ۱۹۳۹، هاوارد فلوری و ارنست چین به این موضوع علاقهمند شدند و تحقیقات جدی بر روی این ماده آغاز گردید. این دو دانشمند همراه با تیمی از محققان، تلاش کردند که از کپک یادشده ماده مؤثر را استخراج کنند. این کار دشوار، اما پیامدهایی بسیار مهم داشت؛ چرا که با آزمایش آن روی بیماران، تأثیر شگفتانگیز پنیسیلین در بهبود بیماریها مشخص شد.
< تا سال ۱۹۴۵، نخستین آنتیبیوتیک جهان بهصورت گسترده و عمومی در دسترس قرار گرفت.
تا سال ۱۹۴۵، نخستین آنتیبیوتیک جهان بهصورت گسترده و عمومی در دسترس قرار گرفت.
آغازی برای تحول جهانی
در سال ۱۹۴۲، الکساندر فلمینگ موفق شد یک بیمار مبتلا به مننژیت را با تزریق پنیسیلین نیمهخالص درمان کند، درمانی که موفقیتآمیز بود. این موفقیت فلمینگ را متقاعد ساخت که تولید پنیسیلین باید به صورت انبوه انجام گیرد. با حمایت دولتهای آمریکا و بریتانیا، تا سال ۱۹۴۵ تولید انبوه این داروی نجاتبخش آغاز گردید و به صورت عمومی در دسترس قرار گرفت.
مراسم افتخار و تأثیر جهانی
در همان سال، فلمینگ به همراه فلوری و چین به دلیل سهم بزرگی که در کشف و تولید پنیسیلین داشتند، جایزه نوبل پزشکی دریافت کردند. از آن زمان، پنیسیلین و مشتقات آن جان میلیونها نفر را از مرگ نجات دادهاند. این دارو همچنین پایهای برای ظهور صدها آنتیبیوتیک دیگر شد. با این حال، استفاده گسترده و گاهاً نادرست از آنتیبیوتیکها به پدیدهای به نام مقاومت باکتریایی منجر شده است که چالش جدیدی در دنیای پزشکی به شمار میآید.
علم ادامه دارد؛ دانشمندان به دنبال یافتن روشهای نوین برای مقابله با ابرباکتریها هستند، از جمله بهرهگیری از ویروسها یا فناوریهای ژنتیکی مانند "CRISPR". اما قطعاً داستان دگرگون شدن دنیای پزشکی با کشف یک کپک سبز در گوشهای از یک آزمایشگاه کوچک، یکی از الهامبخشترین نقطهها در تاریخ علم است.





















برای ارسال نظر کلیک کنید
▼